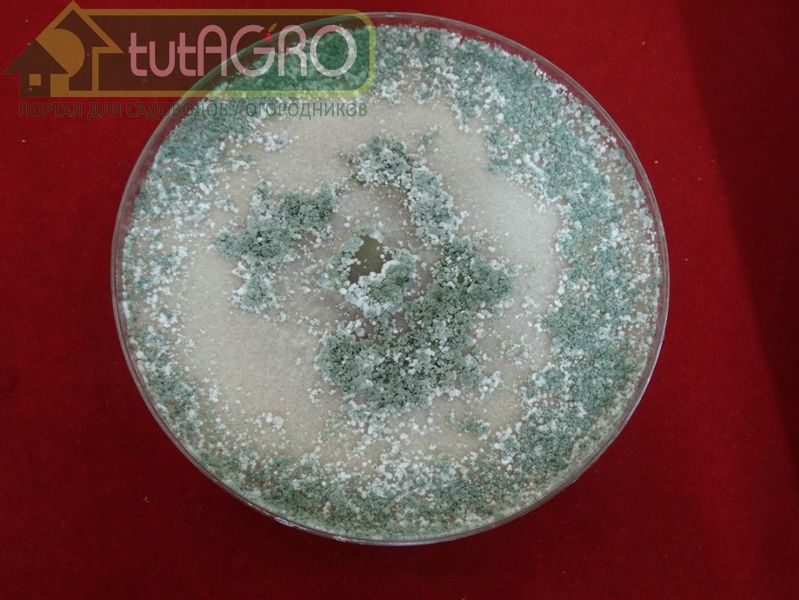
После обрастания всей поверхности «киселя» можно его перемешать и дождаться более обильного роста триходермы - AGROzen

Одним из важных преимуществ биологических препаратов по сравнению с синтетическими является возможность их воспроизводства в домашних условиях. Имея достаточное количество биопрепарата, его можно использовать широко и весьма эффективно.
Микрофлора большинства биопрепаратов неприхотлива и может расти на разнообразных субстратах (перловая крупа, кофейная гуща, чайная заварка, перлит и т. д.). Проблема домашней наработки биопрепаратов состоит в том, что на этих субстратах развивается в том числе и посторонняя микрофлора. Именно поэтому не всегда удачными получаются даже засолки и закваски овощей или кислое молоко.
В микробиологии и биотехнологии очень важно правильно подготовить среду, выбрать хорошую закваску и соблюсти условия, необходимые для развития полезной микрофлоры.
При получении домашней триходермы (как и других биопрепаратов) основным конкурентом полезных микроорганизмов являются дрожжи. Их колонии очень быстро растут, поглощая сахара и выделяя спирт, кислоты и другие вещества, которые тормозят развитие триходермы.

Чтобы воспрепятствовать этой безудержной конкуренции логично использовать такую среду, которая подходила бы триходерме и была бы бесполезна для многих дрожжей. И такая среда существует!
Крахмал – прекрасный источник питательных веществ для триходермы и бесполезная субстанция для многих видов дрожжей.
Потребуется
- Стеклянная банка тщательно вымытая и простерилизованная
- Вода
- Картофельный или кукурузный крахмал
- Любое жидкое удобрение без гуматов
- Поваренная соль
- Триходерма (собственного или промышленного производства)
Рецепт приготовления
На 100 мл воды (при увеличении количества воды все ингредиенты увеличиваются пропорционально) добавить 10 г крахмала, жидкое удобрение 0,5 ч. л., щепотку (0,5 г) поваренной соли. Смесь прокипятить в течение 20 минут, остудить до 30 ℃ или до комнатной температуры. После остывания заселить гель крупинками или суспензией триходермы - достаточно положить (чистым инструментом!) несколько крупинок на поверхность или нанести несколько капель. Закрыть сверху бумажной салфеткой или плотной тканью, крепко обвязать горлышко ниткой или шпагатом. Оставить в теплом месте примерно на неделю. За это время споры прорастут и дадут начало мицелию.
После обрастания всей поверхности «киселя» можно его перемешать и дождаться более обильного роста триходермы. Хранить кисельную триходерму в плотно закрытой банке можно в холодильнике до полугода.
Кисельную триходерму удобно использовать:
- для опрыскиваний и поливов растений в саду и огороде (100 мл на 10 л воды);
- для ускорения созревания компоста и уничтожения в нем патогенной микрофлоры (100 мл на 10 л воды);
- для приготовления препарата на зерновой или любой другой основе (100 мл смешать с 1 кг крупы) - вносите по 0,5 ч. л. в лунку при высадке рассады.
Автор: Иван Русских
Иван Русских рекомендует журнал "Урожайные сотки"!
Только в журнале "Урожайные сотки" Вы можете получать дельные рекомендации, уникальные советы, рецепты от специалиста-биолога, известного блогера Ивана Русских.
Оформите подписку прямо сейчас! Жители Беларуси могут оформить подписку тут. Жители России сюда!
